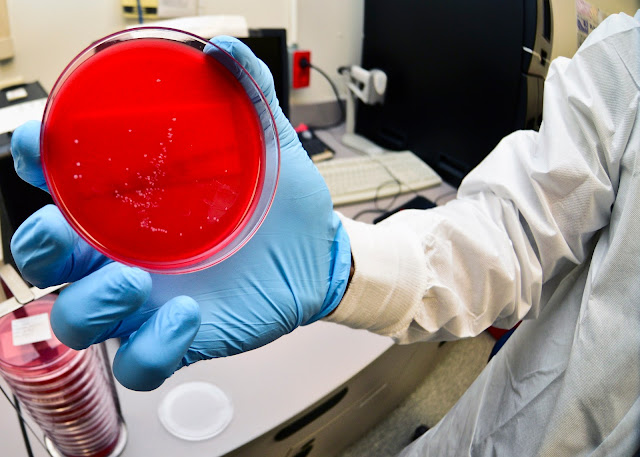

Η μικροβιακή κοινότητα περισσότερων από 100 βακτηριακών ειδών θα μπορούσε να βοηθήσει τους επιστήμονες να μάθουν περισσότερα για τις συνδέσεις μεταξύ του μικροβιώματος και της ανθρώπινης υγείας.
Βασικές
μελέτες την τελευταία δεκαετία έχουν δείξει ότι το μικροβίωμα του εντέρου, η
συλλογή εκατοντάδων βακτηριακών ειδών που ζουν στο ανθρώπινο πεπτικό σύστημα,
επηρεάζει τη νευρική ανάπτυξη, την απόκριση στις ανοσοθεραπείες του καρκίνου
και άλλες πτυχές της υγείας. Αλλά αυτές οι κοινότητες είναι πολύπλοκες και
χωρίς συστηματικούς τρόπους μελέτης των συστατικών, τα ακριβή κύτταρα και τα
μόρια που συνδέονται με ορισμένες ασθένειες παραμένουν ένα μυστήριο.
![]() |
| Μια βακτηριακή κυτταρική καλλιέργεια από το εργαστήριο Του Fischbach. (Πίστωση εικόνας: Λ.Α. Κικέρων) |
Οι
ερευνητές του Πανεπιστημίου του Στάνφορντ έχουν δημιουργήσει το πιο περίπλοκο
και καλά καθορισμένο συνθετικό μικροβίωμα, δημιουργώντας μια κοινότητα με πάνω
από 100 βακτηριακά είδη που μεταμοσχεύθηκαν με επιτυχία σε ποντίκια. Η
δυνατότητα προσθήκης, αφαίρεσης και επεξεργασίας μεμονωμένων ειδών θα επιτρέψει
στους επιστήμονες να κατανοήσουν καλύτερα τους δεσμούς μεταξύ του μικροβιώματος
και της υγείας και τελικά να αναπτύξουν θεραπείες μικροβιώματος πρώτης
κατηγορίας.
Πολλές
βασικές μελέτες μικροβιώματος έχουν γίνει χρησιμοποιώντας μεταμοσχεύσεις
κοπράνων, οι οποίες εισάγουν ολόκληρο το φυσικό μικροβίωμα από τον έναν
οργανισμό στον άλλο. Ενώ οι επιστήμονες συνήθως αποσιωπούν ένα γονίδιο ή
αφαιρούν μια πρωτεΐνη από ένα συγκεκριμένο κύτταρο ή ακόμα και ένα ολόκληρο ποντίκι,
δεν υπάρχει τέτοιο σύνολο εργαλείων για την αφαίρεση ή την τροποποίηση ενός
είδους μεταξύ των εκατοντάδων σε ένα δεδομένο δείγμα κοπράνων.
«Τόσα
πολλά από αυτά που γνωρίζουμε για τη βιολογία, δεν θα γνωρίζαμε αν δεν υπήρχε η
ικανότητα χειρισμού πολύπλοκων βιολογικών συστημάτων αποσπασματικά», δήλωσε
ο Michael
Fischbach, Υπότροφος ινστιτούτου στο Sarafan ChEM-H και αντίστοιχος
συγγραφέας της μελέτης, που δημοσιεύθηκε στο Cell στις
6 Σεπτεμβρίου.
Ο
Fischbach, ο οποίος είναι αναπληρωτής καθηγητής εμβιομηχανικής και
μικροβιολογίας και ανοσολογίας, και άλλοι είδαν μια λύση: Χτίστε ένα μικροβίωμα
από το μηδέν αναπτύσσοντας μεμονωμένα και στη συνέχεια αναμειγνύοντας τα
συστατικά του βακτήρια.
Χτίζοντας
την κιβωτό
Κάθε
κύτταρο στο μικροβίωμα καταλαμβάνει μια συγκεκριμένη λειτουργική θέση,
εκτελώντας αντιδράσεις που διασπούν και δημιουργούν μόρια. Για να χτίσει ένα
μικροβίωμα, η ομάδα έπρεπε να διασφαλίσει ότι το τελικό μείγμα δεν ήταν μόνο
σταθερό, διατηρώντας μια ισορροπία χωρίς κανένα είδος να υπερτερεί των
υπόλοιπων, αλλά και λειτουργικό, εκτελώντας όλες τις ενέργειες ενός πλήρους,
φυσικού μικροβιώματος. Η επιλογή των ειδών που θα συμπεριληφθούν στη συνθετική
τους κοινότητα ήταν επίσης δύσκολη δεδομένης της φυσικής ποικιλομορφίας μεταξύ
των ατόμων. δύο άτομα που επιλέχθηκαν τυχαία μοιράζονται λιγότερο από το ήμισυ
των μικροβιακών γονιδίων τους.
Οι
ερευνητές αποφάσισαν να χτίσουν την αποικία τους από τα πιο διαδεδομένα
βακτήρια και στράφηκαν στο Human Microbiome Project (HMP), μια πρωτοβουλία των
Εθνικών Ινστιτούτων Υγείας για την αλληλούχιση των πλήρων μικροβιακών
γονιδιωμάτων περισσότερων από 300 ενηλίκων.
«Ψάχναμε
για την Κιβωτό του Νώε των βακτηριακών ειδών στο ανθρώπινο έντερο, προσπαθώντας
να βρούμε αυτά που ήταν σχεδόν πάντα εκεί σε οποιοδήποτε άτομο», δήλωσε ο
Fischbach.
Επέλεξαν
πάνω από 100 βακτηριακά στελέχη που υπήρχαν σε τουλάχιστον 20% των ατόμων HMP.
Η προσθήκη μερικών ειδών που χρειάζονταν για κάποιες μεταγενέστερες μελέτες τα
έφερε σε 104 είδη, τα οποία καλλιέργησαν σε μεμονωμένα αποθέματα και στη
συνέχεια αναμείχθηκαν σε μία συνδυασμένη καλλιέργεια για να κάνουν αυτό που
αποκαλούν ανθρώπινη κοινότητα ένα, ή hCom1.
Αν
και ικανοποιημένοι ότι τα στελέχη θα μπορούσαν να συνυπάρχουν στο εργαστήριο,
το πραγματικό τεστ ήταν αν η νέα αποικία τους θα ριζώσει στο έντερο. Εισήγαγαν
το hCom1 σε ποντίκια που είναι προσεκτικά σχεδιασμένα για να μην υπάρχουν
βακτήρια. Το hCom1 ήταν αξιοσημείωτα σταθερό, με το 98% των συστατικών ειδών να
αποικίζουν το έντερο αυτών των ποντικών χωρίς μικρόβια και τα σχετικά επίπεδα
αφθονίας κάθε είδους να παραμένουν σταθερά για δύο μήνες.
Ξένη
εισβολή
Για
να κάνουν την αποικία τους πιο ολοκληρωμένη, οι ερευνητές ήθελαν να βεβαιωθούν
ότι όλες οι ζωτικές λειτουργίες του μικροβιώματος θα εκτελούνταν από ένα ή
περισσότερα είδη. Βασίστηκαν σε μια θεωρία που ονομάζεται αντοχή στον
αποικισμό, η οποία εξηγεί ότι οποιοδήποτε βακτήριο, όταν εισαχθεί σε μια
υπάρχουσα αποικία, θα επιβιώσει μόνο εάν μπορεί να γεμίσει μια θέση που δεν
έχει ήδη καταληφθεί.
Εισάγοντας
ένα πλήρες μικροβίωμα, με τη μορφή ενός ανθρώπινου δείγματος κοπράνων, στην
αποικία τους και παρακολουθώντας τυχόν νέα είδη που εγκαταστάθηκαν, θα
μπορούσαν να δημιουργήσουν μια πιο ολοκληρωμένη κοινότητα.
Μερικοί
ήταν δύσπιστοι ότι αυτό θα λειτουργούσε. «Τα βακτηριακά είδη στο hCom1 είχαν
ζήσει μαζί μόνο για λίγες εβδομάδες», δήλωσε ο Fischbach. «Εδώ ήμασταν,
παρουσιάζοντας μια κοινότητα που συνυπήρχε για μια δεκαετία. Κάποιοι πίστευαν
ότι θα αποδεκατίσουν την αποικία μας».
Είναι
αξιοσημείωτο ότι το hCom1 κράτησε το δικό του και μόνο περίπου το 10% των
κυττάρων στην τελική κοινότητα προήλθε από τη μεταμόσχευση κοπράνων.
Βρήκαν
πάνω από 20 νέα βακτηριακά είδη που εισήχθησαν σε τουλάχιστον δύο από τις τρεις
μελέτες μεταμόσχευσης κοπράνων. Η προσθήκη αυτών στην αρχική τους κοινότητα και
η αφαίρεση εκείνων που απέτυχαν να ριζώσουν στα έντερα των ποντικιών τους έδωσε
μια νέα κοινότητα 119 στελεχών, που ονομάστηκε hCom2. Αυτή η δεύτερη επανάληψη,
που εξακολουθεί να γίνεται από την ατομική ανάπτυξη και στη συνέχεια την
ανάμειξη των συστατικών, έκανε τα ποντίκια ακόμη πιο ανθεκτικά στις προκλήσεις
των κοπράνων από την πρώτη.
Τελική
πρόκληση
Για
να αποδείξει τη χρησιμότητα του συνθετικού μικροβιώματός τους, η ομάδα πήρε
ποντίκια που αποικίστηκαν από hCom2 και τα προκάλεσε με δείγμα E. coli.
Αυτά τα ποντίκια, όπως και εκείνα που αποικίστηκαν με φυσικό μικροβίωμα, αντιστάθηκαν
στη μόλυνση.
Προηγούμενες
μελέτες έχουν δείξει ότι ένα υγιές φυσικό μικροβίωμα οδηγεί σε προστασία, αλλά
ο Fischbach και οι συνεργάτες του θα μπορούσαν να το πάνε ένα βήμα παραπέρα
εξαλείφοντας ή τροποποιώντας επαναληπτικά ορισμένα στελέχη για να προσδιορίσουν
ποια παρέχουν ειδικά προστασία. Βρήκαν αρκετά βασικά βακτήρια και σχεδιάζουν να
διεξαγάγουν περαιτέρω μελέτες για να περιοριστούν στα πιο κρίσιμα είδη.
Ο
Fischbach πιστεύει ότι το hCom2, ή μελλοντικές εκδοχές του, θα επιτρέψουν
παρόμοιες μελέτες αναγωγής που αποκαλύπτουν τους βακτηριακούς παράγοντες που
εμπλέκονται σε άλλους τομείς, όπως οι αποκρίσεις ανοσοθεραπείας.
«Χτίσαμε
αυτή την κοινοπραξία για την ευρύτερη ερευνητική κοινότητα. Θέλουμε να το
πάρουμε σε όσο το δυνατόν περισσότερα χέρια για να έχουμε αντίκτυπο στο
γήπεδο», δήλωσε ο Φίσμπαχ.
Οραματίζεται
επίσης ότι αυτή η μέθοδος οικοδόμησης ενός μικροβιώματος από την αρχή θα
καταστήσει δυνατές τις μηχανικές θεραπείες με βάση το μικροβίωμα στο μέλλον. Ως
διευθυντής της Πρωτοβουλίας
Θεραπειών Μικροβιώματος του Στάνφορντ (MITI), μιας πρωτοβουλίας
που ξεκίνησε
το 2019 από τη Sarafan ChEM-H και το Τμήμα Εμβιομηχανικής, στοχεύει
στη δημιουργία τεχνητών κοινοτήτων που θα μπορούσαν μια μέρα να μεταμοσχευθούν
σε ανθρώπους για τη θεραπεία ή την πρόληψη μιας ποικιλίας ασθενειών.
Ο
Φίσμπαχ είναι μέλος του Στάνφορντ
Bio-X και της Συμμαχίας
Ανθρώπινης Απόδοσης Wu Tsai και είναι ερευνητής βιοχούμπ του Τσαν
Ζούκερμπεργκ. Άλλοι συγγραφείς του Στάνφορντ είναι οι Άλις Τσενγκ, Πο-Γι Χο, Αντρές
Αράντα-Ντίαζ, Φεϊκιάο Γιου, Ξιαντόνγκ Μενγκ, Μιν Γουάνγκ, Μιχαήλ Ιακιβιάκ,
Καζούκι Ναγκασίμα, Αϊσάν
Ζάο, Παλλάβι
Μουρουγκκάρ, Αντβάιτ
Πατίλ, Καταγιόν
Αταμπάχς, Άλισον
Άσλεϊ, Άριελ Μπρούμπαου, Στίβεν Χίγκινμποτομ, Αλεχάντρα Δήμας, Άντονι Σίβερ, Τζάστιν Σόνενμπουργκ και ΚΚ Χουάνγκ.
Το
έργο υποστηρίχθηκε από μια μεταδιδακτορική υποτροφία του Κοσμήτορα, τα Εθνικά
Ινστιτούτα Υγείας, το Ερευνητικό Πρόγραμμα Επιστήμης Ανθρωπίνων Συνόρων, το
Ίδρυμα Astellas για την Έρευνα στις Μεταβολικές Διαταραχές, την Πρωτοβουλία
Θεραπειών Μικροβιώματος του Στάνφορντ, το Εθνικό Ίδρυμα Επιστημών, το Ίδρυμα
Bill and Melinda Gates, το Ίδρυμα Helmsley, το Ιατρικό Ινστιτούτο Howard
Hughes, το Ίδρυμα Leducq, το Πρόγραμμα Επιχορηγήσεων Μεταφραστικής Έρευνας
Stanford-Coulter, Φιλανθρωπίες αντίκτυπου MAC3 και το Κέντρο Ανακάλυψης Allen
στο Στάνφορντ για τη μοντελοποίηση συστημάτων μόλυνσης.